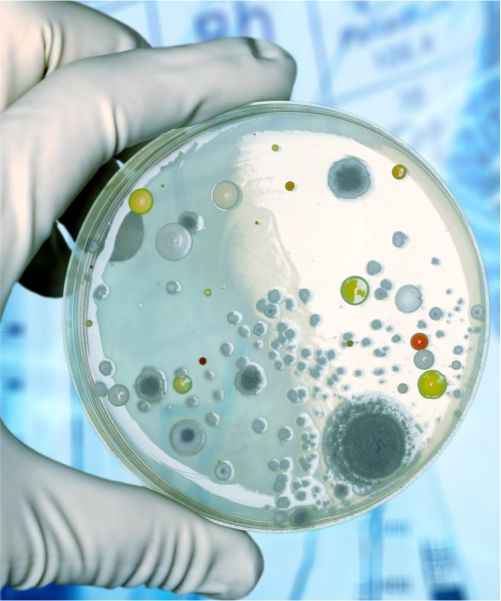
Thumb

COMPLETE BLOOD COUNT
(CBC-24 Test)
HB, TLC, Neutrophil, Lymphocyte, Eosinophil,
Monocyte, Basophil, Platelet Count, Platelet
Larger Cell Ratio, Immature Granulocyte
PCV, PCT, PLCC, RBC, MCV, MCH, MCHC, MPV,
PDW, RDW-SD, RDW-CV, Absolute Neutrophil
Count, Absolute Lymphocyte Count,
Absolute Monocyte Count, Absolute Basophil
Count, Absolute Eosinophil Count, ESR
Book Now
LIVER FUNCTION TEST
11 Tests
SGPT, SGOT, Total Proteins, Albumin, Globulin,
A:G Ratio, Bilirubin-Direct,
Bilirubin Indirect
Bilirubin Total, Serum Protein, SGOT/SGPT
Ratio, Gamma GT


KIDNEY FUNCTION TEST
7 Tests
Urea, Uric Acid, Blood Urea Nitrogen,
Creanine,Urea/ Creanine Ratio, BUN
Creanine Ratio, EGFR


LIPID PROFILE
8 Tests
Total Cholesterol, Triglycerides, HDL, LDL,
VLDL, Total Cholesterol / HDL Cholesterol
Ratio, LDL/HDL Ratio NON/HDL Rato








URINE ROUTINE & MICROSCOPY
19 Tests
Quanty, Urobilinogen, Ketone, RBC’s Casts,
Crystals, Colour, Puss,
Specific Gravity,
Transparency, Ph, Blood, Nitrite, Epithelial, Bacteria,
Urine Protein Albumine, Urine Bilirubin, Urine Glucose, Yeast